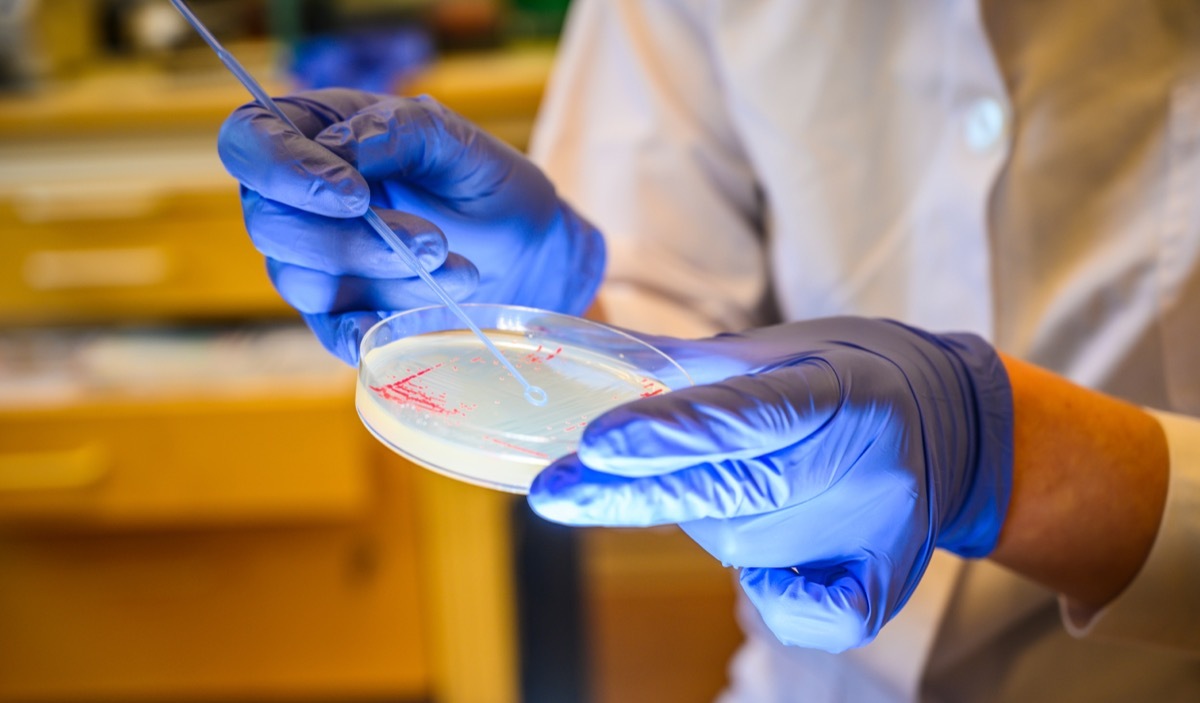
petri dish with e. coli bacteria

Die FDA zieht alle von dieser Firma hergestellten Lebensmittel aus Regalen
Überprüfen Sie Ihren Kühlschrank. Es ist an der Zeit, etwas von dieser Firma zu werfen.
Nichts sagt der Sommer wie die frischen Aromen der mexikanischen Küche - aber wenn Ihre Taco dienstags oder Enchilada täglich eine Seite von Salsa oder Queso beinhalten, könnte Ihre Gesundheit in Gefahr sein. Diese Woche gab die US-amerikanische Food and Drug Administration (FDA) eine Warnung über die Produkte eines bestimmten Unternehmens aufgrund der schwerwiegenden Gesundheitsprobleme, die sie jedem präsentieren können, der sie verbraucht. Lesen Sie weiter, um herauszufinden, ob Sie diese Nahrungsmittel jetzt werfen sollten und was Sie tun sollten, wenn Sie bereits einige der beeinträchtigten Produkte gegessen haben.
VERBUNDEN:Wenn Sie dieses Getränk zu Hause haben, loswerden Sie es jetzt, sagen die Behörden.
Die Produkte von kleinen Luken wurden zunächst als potenziell kontaminiert im Mai identifiziert.

Am 20. Mai, Interstate-Lebensmittelprodukte, die Muttergesellschaft Lakewood, Colorado-basierte Lebensmittelfirma Little Hatch's, initiiert einfreiwilliger Rückruf von Little Hatchs Jalapeño-Frischkäse mit einem Verkaufsbuch von 05/21. Am 28. Mai, nocheine andere Rückrufbewertung wurde für kleine Hatch-Produkte ausgestellt, darunter den Jalapeño-Frischkäse der Marke, der Queso und der spicy Queso. Am 15. Juni, nach internen Tests, die von Interstate-Lebensmittelprodukten durchgeführt wurden, kündigte das Unternehmen der FDA an, dass die gebratenen Chili Salsa der Marke auch erinnert werden sollte.
Die FDA sagt, dass diese Produkte sofort wegwerfen.

Eine von der FDA ausgestellte öffentliche Gesundheitsalarmung am 25. Juni jetzt Vorsichtshinweise dafür, dass die Verbrauchersollte nicht kaufen oder essen irgendein Produkte, die von kleinen Luken hergestellt werden. Die regulatorische Organisation besagt, dass die Verbraucher, während die Filialen noch dabei sind, diese Produkte aus Regalen zu ziehen, die vollständige Produktlinie des Unternehmens steuern, was Jalapeño-Frischkäse-Dip, Queso, würziges Queso, geröstetes Chili-Salsa-Medium und Gebratene Chili Salsa heiß in 13,5-oz verkauft. oder 14-oz. Behälter. Die Produkte wurden an natürlichen Lebensmittelgeschäftsmarkt und dem Glücksmarkt in Denver, Colorado sowie in den gesamten Lebensmittelstandorten in Colorado, Kansas, Missouri, New Mexico, Utah, Texas und Wyoming verkauft.
Die zurückgerufenen Lebensmittel können mit gefährlichen Bakterien kontaminiert sein, die Sie krank machen können.
Die FDA fand Spuren vonListeria Monocytogenes. In den Einzelhandelsproben der abgerufenen Produkte, die eine Inspektion der Fertigungseinrichtungen des Unternehmens einholen. FDA-Ermittler haben festgestellt, dass 23 von 149 ihrer anschließend getesteten Proben das enthieltenKrankheits verursachte Bakterien.
Listeria Monocytogenes. Kann zu Listeriose führen, eine Infektion, die typischerweise grippeartige Symptome verursacht, einschließlich Durchfall, Müdigkeit, Fieber und Muskelschmerzen. Die Zentren für Krankheitssteuerungs- und Prävention (CDC) berichten jedoch, dass der Zustand jedoch verursachen kannErnstere Gesundheitsprobleme, besonders bei schwangeren Individuen, Neugeborenen, älteren Menschen und das immunocompromisierte. Der Zustand führt zu einem Durchschnitt von 260 Todesfällen in den USA in den USA.
Verwandte: Für weitere Produkt-Recall-Warnungen werden direkt an Ihren Posteingang gesendet,Melden Sie sich für unseren täglichen Newsletter an.
Hier ist was zu tun, wenn Sie diese Produkte zu Hause haben.

Wenn Sie kürzlich Produkte von kleinen Lukens gekauft haben, sagt die FDA zuWerf sie weg Sofort und folgen Sie diesen Schritten: "Waschen Sie die Innenwände und Regale des Kühlschranks, Schneidebretter und Arbeitsplatten, und Utensilien, die möglicherweise mit kontaminierten Lebensmitteln Kontakt aufgenommen haben; dann mit einer Lösung von einem Esslöffel Chlorbleiche zu einer Gallone heißen Wasser, trocken mit einem sauberen Tuch oder einem Papiertuch, das noch nicht verwendet wurde. "
Wenn Sie diese Produkte konsumiert haben und sich um Ihre Gesundheit anbieten oder Symptome der Krankheit erleben, wenden Sie sich sofort an Ihren Arzt.
VERBUNDEN:Wenn Sie eine dieser 6 Ergänzungen annehmen, hat die FDA eine neue Warnung für Sie.
Sehen Sie die Tochter von Ewan McGregor auf dem roten Teppich nach dem unheimlichen Hundangriff
schälen die Schichten von Priyankas Privatleben und mütterlicher Reise